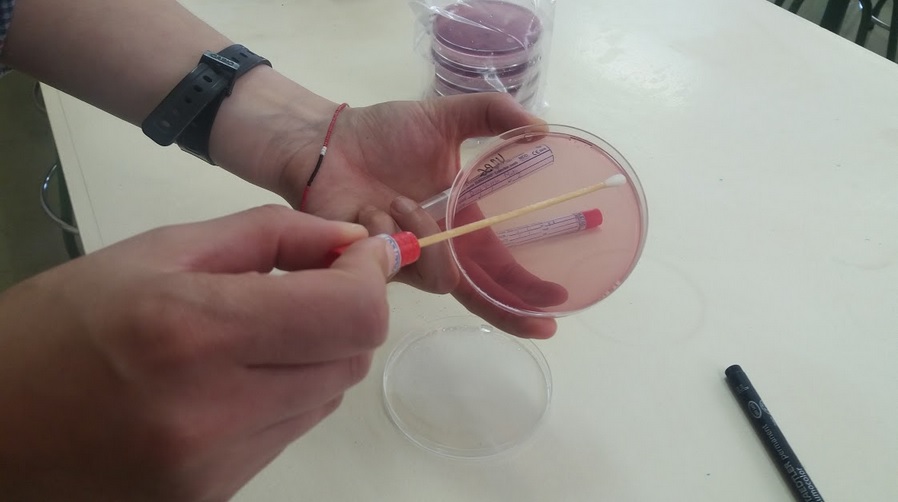

O laboratorio de Ciencias é un lugar especial, está cheo de aparellos complexos, material de vidro e reactivos químicos. Por ese motivo precisa dunhas regras de uso que nos dean seguridade.
Normas de seguridade no laboratorio
Facemos a Ciencia
Para comprender ben esas normas imos traballalas mediante a realización de vídeos curtos, máximo un minuto, nos que enfrontemos un bo uso e un mal uso do espazo e do material de laboratorio.
Para comprender ben esas normas imos traballalas mediante a realización de vídeos curtos, máximo un minuto, nos que enfrontemos un bo uso e un mal uso do espazo e do material de laboratorio.
Cada grupo de alumnos escollerá unha norma e gravará un vídeo primeiro demostrando como sería o mal uso e despois como sería o bo. (Exemplos: Como rachar todas as normas básica do laboratorio, Orde no laboratorio)
As normas a ilustrar son:
1. Levar sempre a roupa e o pelo recollido.
2. Non levantarse baixo ningún concepto sen o permiso expreso da profesora.
3. Manter a mesa de traballo libre de todo o que non sexa necesario.
4. Non utilizar o material de laboratorio máis que para os usos indicados na experiencia.
5. Acender os chisqueiros só no momento no que sexa necesario e apagalos inmediatamente unha vez terminemos de utilizalos.
6. Ao quentar os tubos de ensaio directamente sobre a chama, poñelos inclinados de forma que non apunten a outro compañeiro. Cando se quenten recipientes é mellor facelo de forma intermitente.
7. Non comer nin beber durante a permanencia no laboratorio.
8. Traballar sobre os materiais de forma ordenada. Deixar a mesa e todo o material ben limpo e colocado no seu sitio.
9. Ao verter líquidos dun recipiente a outro manter sempre o recipiente receptor sobre a mesa. Non se deben verter directamente sobre o recipente, senón deixalo esvarar suavemente polas paredes do mesmo.
10. Non enchufar aparellos eléctricos coas mans húmidas.
11. Comunicarlle inmediatamente ao profesor calquera accidente (cortaduras, queimaduras, etc.) así como as posibles anomalías que se observen no material a utilizar.
12. Antes de empezar, ler atentamente o texto da práctica e preguntar posibles dúbidas.
Licenciado baixo a Licenza Creative Commons Recoñecemento Compartir igual 4.0